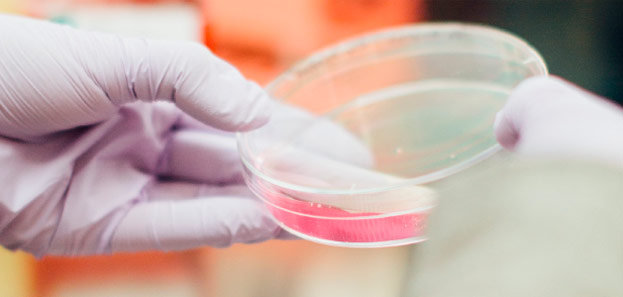

Quem Somos

Nossos Exames
Conheça os exames que realizamos
Nossos Convênios
Para informações de valores para procedimentos particulares,
entre em contato pelo telefone/WhatsApp (55) 3512.6330.

Conheça os exames que realizamos
Para informações de valores para procedimentos particulares,
entre em contato pelo telefone/WhatsApp (55) 3512.6330.

